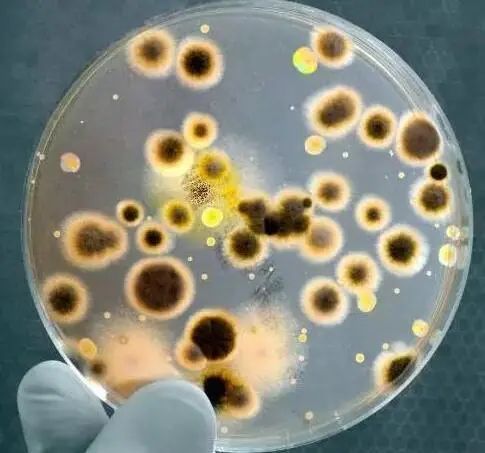

很多人都知道发霉的食物不能吃,因为除了异源微生物引起的肠道不适,微生物生长繁殖过程中产生的次生代谢产物——真菌毒素造成的急性和慢性食物中毒,危害更为严重。此外, 真菌毒素还有致癌性,致突变等危害。
真菌毒素一旦污染难以去除
1960年,英国发生了10万只火鸡离奇死亡事件,经调查发现是因为饲料受到了真菌毒素的污染而导致的动物死亡。从此开始,真菌毒素的危害逐渐被人类发现。
真菌毒素是由真菌侵染谷物、水果等农产品及其制品产生的次生代谢产物,迄今为止已发现400多种类型。真菌毒素一般通过食物进入动物和人类体内,长期食用会对消化系统、免疫系统和神经系统等产生多种毒性。真菌毒素具有耐腐蚀和耐高温的性质,在培育、种植、加工、运输、烹饪等食物生产的各个环节都可能污染食物且难以清除。

真菌毒素进入人体的路径
不同食物易滋生的真菌不一样
粮食、水果等食物无论是在生长阶段还是成熟后的储存阶段,如处于温度适宜(25-35℃)的潮湿环境中,非常容易滋生真菌微生物,当这些真菌带有产毒基因且环境条件适宜的时候,“真菌毒素”就会产生,从而导致食物被污染。
由于食物种类不同,滋生的真菌存在差别,真菌毒素种类也不同。花生及其制品易被黄曲霉侵染,受到黄曲霉毒素B1(AFB1)的污染。小麦及其制品易滋生禾谷镰刀菌,受到脱氧雪腐镰刀菌烯醇(DON)和玉米赤霉烯酮(ZEN)的污染。玉米及其制品易滋生串珠镰刀菌和禾谷镰刀菌,被伏马菌素B1(FB1)和玉米赤霉烯酮(ZEN)污染。苹果、山楂及其制品易被青霉侵染,从而被展青霉素污染。
此外,真菌毒素可通过代谢污染动物食品,如黄曲霉毒素B1被奶牛吃下后代谢可产生M1,同样对人体有害。

常见发霉食物
常见真菌毒素种类及其主要危害

日常生活中注意购买渠道、妥善保存食物
_ | (1)由于真菌毒素能够渗透入食物内部且耐高温,常规的烹饪方法无法消除它,因此,降低真菌毒素危害的关键是防止食物发霉。
储存食物时要注意通风、干燥和低温,防止真菌的生长和产毒。 可采用抽真空、充氮气等方法储存食物,避免真菌滋生。 尽量购买小包装食物,避免大量购买后食物储存不当,滋生真菌,产生毒素。 除了观察食品外观,闻味道以外,注意食物保质期来防霉变更具可操作性。 |
| _ | (2)由于真菌毒素具有体内蓄积性,畜禽动物食用被真菌毒素污染的饲料后,毒素会在体内蓄积。因此,在购买肉、蛋、奶等畜禽产品时,请购买正规厂家的产品。 |
| _ | (3)及时清理发霉的食物,以免真菌继续侵染更多食物,造成真菌毒素污染扩散。值得注意的是,真菌毒素的污染范围和肉眼看到的并不一致。对于已经霉变食品,即使去除肉眼可见的霉变部分,也可能存在真菌毒素,建议全部丢弃。 |
如误食后引起不适,请及时就医,
并向医生说明食用霉变食品的情况,
以便及时有效救治。
最重要的是,一旦食物发霉,不要食用!不要食用!不要食用!
参考文献:
[1] 黄天培, 何佩茹, 潘洁茹, 等. 食品常见真菌毒素的危害及其防止措施 [J]. 生物安全学报, 2011, 20(02): 108-12.
[2] 范楷, 祭芳, 徐剑宏, 等. 长三角地区市场常见农产品中40种真菌毒素的污染状况和特征分析 [J]. 中国农业科学, 2021, 54(13): 2870-84.
[3] 李文廷, 申颖, 李洁, 等. 2019年云南市售大米真菌毒素污染水平及风险评估 [J]. 食品安全质量检测学报, 2021, 12(14): 5861-9.
[4] 任思瑞, 周鸿媛, 刘榕, 等. 粮食真菌毒素的生殖、发育与遗传毒性:现状与展望 [J]. 生态毒理学报: 1-16.
[5] 巫婷玉, 周芳月, 马嫚. 真菌毒素与人类疾病 [J]. 饮食科学, 2018, (16): 155.
供 稿:于 松
编 辑:施青岑
审 稿:熊丽蓓 陆冬磊 冯晓刚